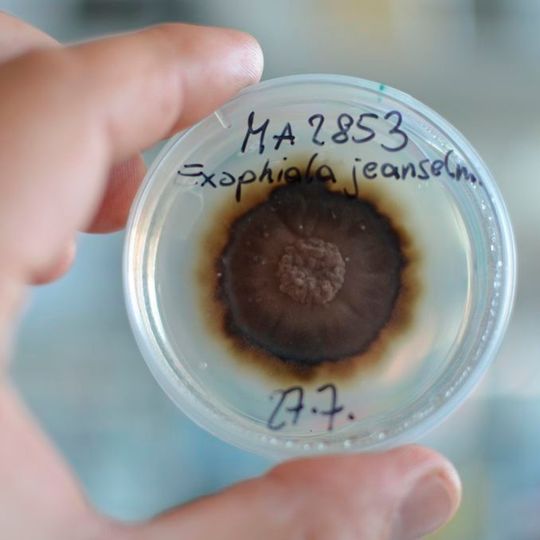

Die enorme Stressresistenz der schwarzen Pilze Schwarze Pilze – Gesundheitsgefahr im Geschirrspüler?
Kleine schwarze Pilze sind die wahren Größen unter den Mikroorganismen, denn sie sind extrem stressresistent. Das ermöglichen bisher unbekannte Proteine und spezielle Zellprozesse wie eine Wiener Forschergruppe mit Unterstützung des Wissenschaftsfonds FWF herausgefunden hat.
Anbieter zum Thema
Wien – Er ist ein echter Überlebenskünstler: Kälte setzt ihm ebenso wenig zu wie Hitze. Ob viel oder wenig Sauerstoff, ob es nass, salzig, trocken oder der Boden verseucht ist – der schwarze Pilz bleibt gelassen und fühlt sich in jeder noch so widrigen Umgebung wohl. Wie schafft er das?
„Die große Überraschung war, dass die Pilze so gut wie keine Stressreaktion zeigen. Das heißt, dass sie per se etwas haben, was sie resistent macht“, erzählt Katja Sterflinger. Mit Unterstützung des Wissenschaftsfonds FWF hat die Mikrobiologin in einer Klimakammer unterschiedliche Stresssituationen simuliert, wie sie die Pilze in extremen Regionen wie etwa in der Arktis oder in der Wüste erleben. Dabei hat sie zunächst beobachtet, wie die Zellen des Pilzes, genau genommen die Proteine (Eiweiße), auf Kälte, Hitze, Ozon oder Trockenheit reagieren.
Einzigartiges „Proteinwerkzeug“ ermöglicht extreme Stressresistenz
Katja Sterflinger leitet das „Extremophile Center“ am Vienna Institute of Biotechnology (VIBT) der Universität für Bodenkultur in Wien. Die für das Institut eigens gebaute Klimakammer und modernste Sequenziertechnologien haben es erstmals ermöglicht, die Proteine des schwarzen Pilzes zu identifizieren. „Das war sehr schwierig, weil diese mit nichts vergleichbar oder ident sind, was wir bisher kannten“, so Sterflinger.
Jetzt wissen die Forscher, dass die „mikrokolonialen Pilze“, so der Fachausdruck, eine eigene Proteinausstattung haben, die es ihnen ermöglicht, sowohl bei null Grad Celsius wie auch bei 45 Grad zu wachsen. Sogar eine Reise zum Mars haben die Mikroben überlebt. Dazu ist ein leichtes „Finetuning“ in der Zelle ausreichend. „Je nachdem, ob es kalt oder heiß ist, bewegt sich der Pilz ein wenig. Das sind aber nur Feineinstellungen“, erklärt Katja Sterflinger. Das ist durchaus geschickt von ihm, weil dramatische Wechsel Energie verbrauchen. Das muss er gar nicht und bleibt so selbst in nährstoffarmen Umgebungen wie am Gletscher oder auf Gestein aktiv.
Birgt die nicht-kodierende RNA das Geheimnis?
In einem nächsten Schritt hat das Team um Sterflinger die gewonnenen Proteindaten mit den Transkriptomdaten abgeglichen, das heißt den Ablauf der zellulären Prozesse analysiert. Dabei hat die Forschergruppe entdeckt, dass das Geheimnis der Zelle scheinbar weniger in den Proteinen als vielmehr in der nicht-kodierenden RNA steckt. Diese Moleküle sind in der Zelle aktiv, ohne in Proteine übersetzt zu werden. Ihre biologische Funktion war bis vor Kurzem noch weitgehend unbekannt. Inzwischen weiß man, dass sie bei der Regulation verschiedenster Prozesse in der Zelle eine wichtige Rolle spielen. Schließlich werden nur zwei Prozent des genetischen Materials, das aktiv abgelesen wird, in Proteine übersetzt.
(ID:44376725)

